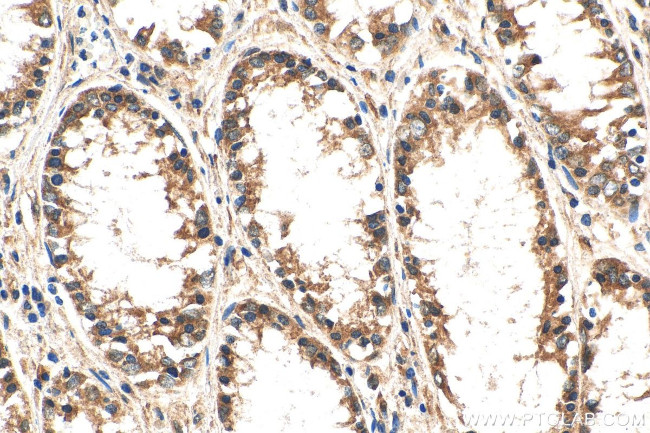
SVCT2 Antibody in Immunohistochemistry (Paraffin) (IHC (P))

Search
Proteintech
SVCT2 Polyclonal Antibody
{{$productOrderCtrl.translations['antibody.pdp.commerceCard.promotion.promotions']}}
{{$productOrderCtrl.translations['antibody.pdp.commerceCard.promotion.viewpromo']}}
{{$productOrderCtrl.translations['antibody.pdp.commerceCard.promotion.promocode']}}: {{promo.promoCode}} {{promo.promoTitle}} {{promo.promoDescription}}. {{$productOrderCtrl.translations['antibody.pdp.commerceCard.promotion.learnmore']}}
产品信息
27019-1-AP150UL
种属反应
宿主/亚型
分类
类型
偶联物
形式
浓度
规格
纯化类型
保存液
内含物
保存条件
运输条件
靶标信息
The absorption of vitamin C into the body and its distribution to organs requires two sodium-dependent vitamin C transporters. This gene encodes one of the two required transporters and the encoded protein accounts for tissue-specific uptake of vitamin C. Previously, this gene had an official symbol of SLC23A1.The absorption of vitamin C into the body and its distribution to organs requires two sodium-dependent vitamin C transporters. This gene encodes one of the two required transporters and the encoded protein accounts for tissue-specific uptake of vitamin C. Previously, this gene had an official symbol of SLC23A1.
仅用于科研。不用于诊断过程。未经明确授权不得转售。
篇参考文献 (0)
生物信息学
蛋白别名: ascorbic acid membrane transporter; SVCT2; hSVCT2; KIAA0238; membrane transporter; mSVCT2; Na(+)/L-ascorbic acid transporter 2; NBTL1; Nucleobase transporter-like 1 protein; sodium-coupled ascorbic acid transporter 2; Sodium-dependent vitamin C transporter 2; sodium-dependent vitamin C transporter-2; solute carrier family 23 (ascorbic acid transporter), member 2; solute carrier family 23 (nucleobase transporters), member 1; solute carrier family 23 (nucleobase transporters), member 2; Solute carrier family 23 member 2; SVCT-2; testicular secretory protein Li 48; unnamed protein product; Yolk sac permease-like molecule 2; YSPL2
基因别名: AI844736; KIAA0238; mKIAA0238; NBTL1; SLC23A1; SLC23A2; SVCT2; YSPL2; YSPL3
UniProt ID: (Human) Q9UGH3, (Mouse) Q9EPR4, (Rat) Q9WTW8
Entrez Gene ID: (Human) 9962, (Mouse) 54338, (Rat) 50622